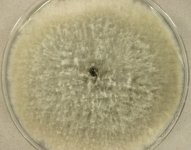

Search Details
| UAMH Number: | 10328 |
|---|---|
| Species Name: | Botryosphaeria dothidea |
| Type: | Botryosphaeria populi |
| Synonyms: | Botryosphaeria auasmontanum / Botryosphaeria berengeriana / Botryosphaeria berengeriana subsp. berengeriana / Botryosphaeria berengeriana var. acerina / Botryosphaeria berengeriana var. berengeriana / Botryosphaeria berengeriana var. weigelae / Botryosphaeria berengeriana var. weigeliae / Botryosphaeria dothidea var. dothidea / Botryosphaeria minutispermatia / Botryosphaeria qinlingensis / Botryosphaeria quercus / Botryosphaeria sinensia / Botryosphaeria sinensis / Botryosphaeria wangensis / Caumadothis dothidea / Cryptosporium aesculi / Diaporthe coronillae / Discella aesculi / Dothiorella coronillae / Fusicoccum aesculi / Fusicoccum coronillae / Macrophomopsis coronillae / Melanops berengeriana / Melanops suberumpens / Melanops weigelae / Phyllosticta divergens / Physalospora suberumpens / Sphaeria coronillae / Sphaeria dothidea |
| Taxonomy: | FUNGI Ascomycota, Dothideomycetes, Botryosphaeriales, Botryosphaeriaceae |
| Strain History: | A.J.L. Phillips (CAP 086) -> CBS 110300 -> UAMH |
| Substrate: | shoot of Populus nigra | Location: | PORTUGAL Sao Vitor, Braga, Minho (GEO: 41.542,-8.405) |
| Isolator: | A.J.L. Phillips (CAP 086) |
| Isolation Date: | 1999-12-29 |
| Date Received: | 2003-07-29 |
| Characters: | (Click for publications citing UAMH 10328) |
| Compounds: | |
| Cross Reference: | CBS 110300 // LISE 94446 (Herb.) |
| Collections: | Living Strains; Dried Herbarium Material |
| Pathogenic Potential: | Human: no | Animal: no | Plant: yes |
| Biosafety Risk Group: | RG1 (check the PHAC ePATHogen Risk Group Database for updates) |
| Regulatory Requirements: | Canadian requesters must provide PHAC Pathogen and Toxin License Number (see: https://www.canada.ca/en/public-health/services/laboratory-biosafety-biosecurity/licensing-program.html) prior to shipment. International requesters must provide all legally required importation documentation prior to shipment. Plant pathogenicity status may be verified by using the USDA Agricultural Research Service (ARS) Fungal Database |
| MycoBank ID: | 183247 |
| Sequences: | >UAMH10328_UAMH_ITS ACCGAGTTGATTCGGGCTCCGGCCCGATCCTCCCACCCTTTGTGTACCTACCTCTGTTGCTTTGGCGGGCCGCGGTCCTCCGCGGCCGGCCCCCCTCCCCGGGGGGTGGCCAGCGCCCGCCAGAGGACCATCAAACTCCAGTCAGTAAACGATGCAGTCTGAAAAACGATTTAATAAACTAAAACTTTCAACAACGGATCTCTTGGTTCTGGCATCGATGAAGAACGCAGCGAAATGCGATAAGTAATGTGAATTGCAGAATTCAGTGAATCATCGAATCTTTGAACGCACATTGCGCCCTTTGGTATTCCGAAGGGCATGCCTGTTCGAGCGTCATTACAACCCTCAAGCTCTGCTTGGTATTGGGCACCGTCCTTTGCGGGCGCGCCTCAAAGACCTCGGCGGTGGCGTCTTGCCTCAAGCGTAGTAGAACATACATCTCGCTTCGGAGCGCAGGGCGTCGCCCGCCGGACGAACCTTCTGAACTTTTCTCAAGGTTGACCTCGGATCAGGTAGGGATACCCGCTGAA >UAMH10328_DQ377851_LSU CAACAGGGATTGCCTTAGTAACGGCGAGTGAAGCGGCAACAGCTCAAATTTGAAAGCTGGCTCCTTTGGAGTCCGCGTTGTAATTTGTAGAGGATGATTCGGCAAGGGCTCCCGCCTAAGTCTCCTGGAACGGAGCGTCATAGAGGGTGAGAATCCCGTATGCGGTGGGCTGCCTAAGCCATGTGAATCTCCTTCGACGAGTCGAGTTGTTTGGGAATGCAGCTCTAAATGGGAGGTAAATTTCTTCTAAAGCTAAATACCGGCCAGAGACCGATAGCGCACAAGTAGAGTGATCGAAAGATGAAAAGCACTTTGGAAAGAGAGTTAAAAAGTACGTGAAATTGTTGAAAGGGAAGCGCTTGCAGCCAGACTTGTCCGCAGTTGCTCAGCCGGTCTCCTGACCGGTGTACTCTTCTGCGGCCAGGCCAGCATCAGTTCGGGCGGTCGGATAAAGACCTCGGGAATGTAGCTCCTCTCGGGGAGTGTTATAGCCCGGGGTGGAATGCGGCCAGCCTGGACTGAGGATCTCGCTTCGGCTAGGATGCTGGCGTAATGGCTGTAAGCGGCCCGTCTTGAAACACGGACCAAGGAGTCTAACATCTATGCGAGTGTTTGGGTGTCAAACCCATGCGCGTAATGAAAGTGAACGGAGGTGGGAACCCTCACGGGTGCACCATCGACCGATCCTGATGTCTTCGGATGGATTTGAGTAAGAGCATAGCTGTTGGGACCCGAAAGATGGTGAACTATGCCTGAATAGGTTGAAGCCAGAGGAAACTCTGGTGGAGGCTCGCAGCGGTTCTGACGTGCAAATCGATCGTCAAATTTGGGTATAGGGGCGAAAGACTAATCG |
IMAGES: